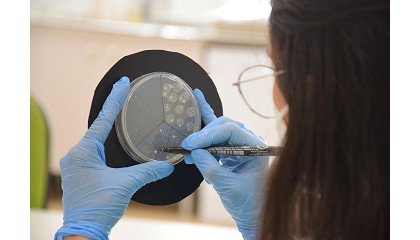

Resultados de la búsqueda "tutorias"
El Colegio Virgen de Europa convierte la convivencia en el eje de su proyecto educativo - 13/11/2025

tutoría entre iguales y la mejora personal para fomentar el respeto, la tolerancia y el bienestar en toda la comunidad educativa. Redacción Interempresas Según el informe de la Fundación COTEC
INTEF abre convocatoria de 8 350 plazas para cursos tutorizados en línea en septiembre de 2025 - 01/08/2025

tutorías personalizadas para el profesorado de enseñanzas no universitarias, con plazo de inscripción entre el 5 y el 24 de junio de 2025. Redacción Interempresas El Instituto Nacional de Tecnologías
Nunsys Group crea las Becas Sof.ia para fomentar el talento femenino STEM - 11/02/2026

tutoría trimestrales de carácter individual con empleadas de Nunsys Group de perfil tecnológico. Esta mentoría, con un acercamiento motivacional y laboral, se completará facilitando a las beneficiarias la realización de prácticas
Davante encabeza el Ranking FP 2025 con su nueva FP Plus - 25/07/2025

tutorías personalizadas en vivo potencia el desarrollo de competencias técnicas, al tiempo que fomenta la autonomía y el compromiso con el propio aprendizaje. El caso del FP Transporte y logística
Ecoembes lanza la XV edición del Circular Talent Lab para impulsar la innovación joven en economía circular - 02/07/2025

tutoría de profesionales expertos en innovación ambiental, que han guiado los procesos desde la conceptualización de la idea hasta su validación en entornos reales. Diversidad como motor de creatividad e innovación
Un trabajo sobre vegetación urbana y gestión de inundaciones representará a España en la final internacional del Stockholm Junior Water Prize 2025 - 13/06/2025

tutoría de la profesora Ana B. Yuste Martínez y tiene como objetivo ofrecer a las ciudades una herramienta sencilla para mejorar la gestión de inundaciones, con el fin de hacerlas
Llega Supercademy, la plataforma de clases particulares personalizadas con IA - 09/09/2024

tutorías en un sector de aproximadamente 40.000 millones de euros y 114 millones de clientes. Redacción Interempresas En este contexto -y con motivo del inicio del nuevo curso escolar- irrumpe
Google selecciona tres empresas españolas para su programa 'AI for Cybersecurity' - 13/02/2025

tutoría, formación y recursos de Google para ayudarles a ampliar sus soluciones basadas en IA y hacer del mundo un lugar más seguro. El programa, de un año de duración
Alltech continúa apoyando el Programa de Tutorías de Mujeres en la Alimentación y la Agricultura - 22/12/2022

Tutorías de Mujeres en la Alimentación y la Agricultura - 22/12/2022: Las solicitudes ya están abiertas para el año 2023 Alltech continúa apoyando el Programa de Tutorías de Mujeres en la Alimentación
Sage lanza Sage AI Training, un programa para formar a colectivos vulnerables en habilidades de IA - 13/03/2025

tutorías, masterclasses técnicas y participación en proyectos finales. En un país con casi 13 millones de personas en riesgo de exclusión social o pobreza no podemos quedarnos de brazos cruzados
50 escuelas europeas estrenan el proyecto piloto AI Classroom de Acer e Intel - 24/09/2025

tutoría personalizada para mejorar las experiencias de aprendizaje. Optimizar los sistemas de gestión de la enseñanza, ayudando a los profesores en tareas administrativas. Ayudar a los educadores en la planificación
ANOVE y CIHEAM Zaragoza impulsarán la innovación vegetal y la formación agroalimentaria - 27/06/2025
tutorías profesionales. Asimismo, las partes se comprometen a apoyarse mutuamente en acciones de difusión y transferencia de resultados de proyectos de investigación, desarrollo e innovación, así como a participar en comisiones
Entrevista a Sergio Alart, director de Maritime Blue Growth - 10/09/2025

tutorías con consultores europeos especializados y un punto de encuentro exclusivo durante el evento. Esta iniciativa está impulsada por BOld, entidad con amplia experiencia en programas europeos como BlueInvest y EUDIS
Wolters Kluwer y CEF-Udima colaboran para potenciar la formación continua - 09/12/2024

tutorías y clases en directo, según informan en una nota de prensa fuentes de la empresa. La firma del convenio establece una alianza estratégica que permite mejorar el aprendizaje de los estudiantes
La educación emocional se afianza como clave del éxito académico y del bienestar en las aulas - 26/11/2025

tutoría en las que se trabaja la empatía, estilos de comunicación y búsqueda de soluciones, entre otras habilidades de convivencia, fortaleciendo así la cultura emocional en toda la comunidad educativa
Brico Depôt refuerza la formación de sus empleados a través de su nuevo programa de mentoring - 17/04/2024

tutorías para los empleados cuyo objetivo principal es la transferencia de conocimientos técnicos, organizacionales, de liderazgo o soft skills para acelerar el proceso de desarrollo personal y profesional de las personas
Inteligencia artificial y analítica educativa: hacia un aprendizaje personalizado y eficiente - 16/09/2025

tiempo real. Analítica de desempeño y engagement en clases híbridas. Herramientas de predicción de riesgos de abandono o bajo rendimiento académico. Plataformas de tutoría virtual con recomendaciones personalizadas de contenidos.
Brand Licensing Europe presenta un programa de apoyo para minoristas y fabricantes - 03/09/2024

tutoría para minoristas. Esta sesión informal ofrecerá a los minoristas la oportunidad de conocer al equipo que está detrás del Programa de tutoría para minoristas de BLE y saber cómo
Las academias online de oposiciones, una alternativa eficaz para conseguir una plaza en la Administración - 07/02/2025

tutorías especializadas. Estas características han hecho que la formación a distancia no solo iguale a la enseñanza presencial en efectividad, sino que en muchos casos la supere. Por qué elegir
Llega a España el 'Reto Europeo a la Bioeconomía Circular' - 05/06/2024

tutorías para evolucionar su idea en el Parque Científico de la Universidad de Valladolid y pasarán a la final de 2025 junto con otras nueve candidaturas del resto de Europa
